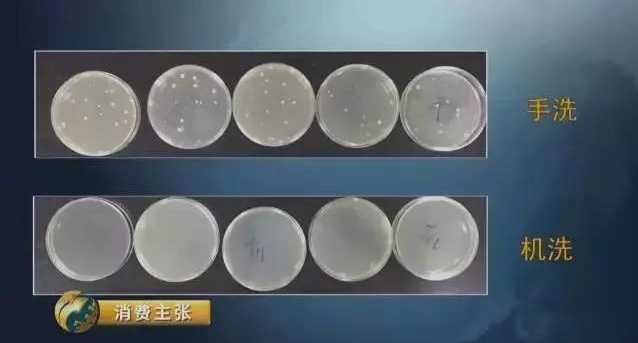

? 微博視頻曝光新聞 日前,微博網名“花總丟了金箍棒”的博主發布了一段五星酒店衛生亂象的視頻,再次引發人們對國內酒店衛生狀況的質疑。視頻中被曝光的酒店,無一例外都存在用同一塊臟抹布、顧客用過的臟浴巾等擦拭杯子、洗手臺、鏡面等衛生亂象。而視頻曝出之后部分酒店已向公眾致歉,有的更是面臨高達3萬以上的罰款。




高星級酒店的高標準、嚴要求哪去了?為什么不用專業的智能商用洗碗機清洗餐具,而要用臟抹布擦?我想如果管理者能預知被曝光、開罰單,一定會用商用洗碗機洗吧!如今不單面臨罰款,企業形象也大大受損。

據統計,目前至少10%以上的傳染病是通過公共餐飲具傳播的,因此餐具衛生尤為重要。現在我們外出就餐會習慣性得用開水燙一下碗筷,原因是雖然碗筷是用塑料薄膜包裝的,但到底干不干凈我們肉眼無法辨認。
所以從2018年7月開始,我國成都市衛生計生監督機構作為試點,將通過遠程視頻監控手段密切關注餐飲具集消企業的生產狀況,市民也可通過二維碼獲取相關衛生檢測報告,餐飲具到底衛不衛生,手機掃一掃就知道了。

成都大邑縣一家餐飲具集中消毒單位的在線監控情況
國家認可
2018年5月,國家市場監督總局的文件直接表達了對洗碗機的認可,在其刊發的《市場監管總局關于印發餐飲服務明廚亮灶工作指導意見的通知》中,認定使用洗碗機進行清洗消毒的情況是無需進行視頻監控,這無疑是對洗碗機的認可。
看上去干凈,就真的干凈嗎
我們對比下手洗和洗碗機清洗,餐具看上去可能都挺干凈的。來看一下央視之前做的測評。

看上去確實手洗和機洗洗出來的餐具效果差不多,那我們來看下餐具的檢測結果。
對比結果不言而喻,洗碗機清洗餐具檢測不到細菌,而手洗檢測到我們肉眼看不見的細菌。